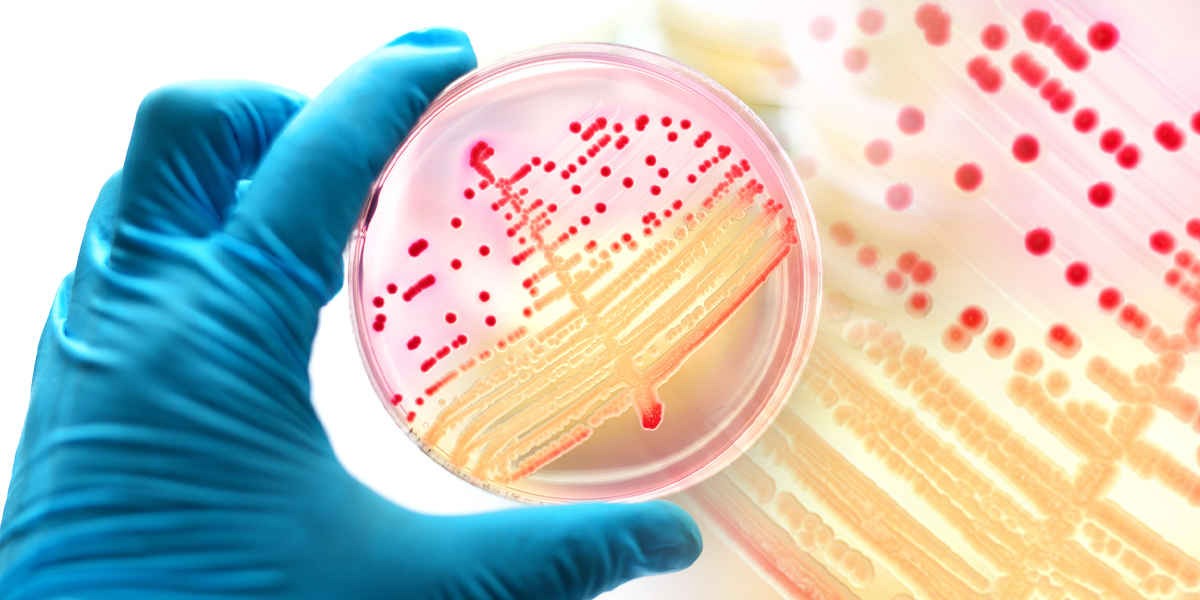

Une étude menée par l’Université Aston, l’Université de Birmingham et Killgerm Chemicals Ltd.
Les arthropodes sont un embranchement qui regroupe notamment les insectes, les arachnides, les mille-pattes, les scorpions, et les crustacés
Une étude apporte de nouvelles informations sur les arthropodes domestiques en tant que réservoirs potentiels de maladies infectieuses en raison de leur portage de bactéries.
L’étude a été conduite par le Dr Federica Boiocchi, durant son doctorat, sous la supervision du professeur Anthony Hilton de l’université Aston et du Dr Matthew Davies de Killgerm Chemicals Ltd. L’objectif était d’acquérir une connaissance approfondie de la communauté des arthropodes d’intérieur, de la diversité des bactéries qu’ils transportent et de leur rôle potentiel en tant que vecteurs de maladies. Il s’agit d’un domaine de recherche largement inexploré et les résultats sont donc particulièrement intéressants.
Qu’ont fait les scientifiques ?
Federica a étudié la communauté d’arthropodes et la diversité du microbiote associé dans vingt environnements intérieurs. Ces environnements ont été échantillonnés sur une période de douze mois, dans des foyers urbains et suburbains. Des « scientifiques citoyens », contributeurs bénévoles à la recherche scientifique, ont été recrutés dans les Midlands de l’Ouest (Royaume-Uni). Ces « scientifiques citoyens » ont joué un rôle crucial dans la réussite du projet. La diversité des arthropodes a été comparée d’un environnement à l’autre et au cours des mois d’échantillonnage. Les bactéries externes (exosquelette) et internes (intestin) associées aux arthropodes capturés vivants ont été évaluées à l’aide d’une approche traditionnelle basée sur la culture microbienne et d’une approche de métabarcoding (une technique de catalogage et d’identification moléculaire) non biaisée.
Qu’ont-ils trouvé ?
Pour la première fois, les chercheurs ont décrit les bactéries externes et internes de 14 familles d’arthropodes présentes dans les environnements intérieurs. L’une des principales conclusions est que les bactéries externes et internes sont des agents pathogènes opportunistes potentiels pour l’homme, avec des implications potentielles pour la santé publique.
Au cours de la période de 12 mois, 215 arthropodes ont été identifiés. Les Pholcidae (araignées de cave) sont la famille la plus fréquente, représentant 33,5 % des captures, suivie des Coccinellidae (coccinelles ; 32,1 %) et des Lepismatidae (lépismes, ou « poissons d’argent » ; 12,1%). Parmi les exemples plus rares, on trouve les Chironomidae (moucherons non piqueurs ; 6%), les Calliphoridae (mouches vertes et bleues ; 3,3%), les Culicidae (moustiques ; 2,3%), les Pyralidae (pyrales ; 1,9%), les Tipulidae (tipules, ou « cousins » ; 1,4%), les Blattidae (blattes ; 0,9%), les Noctuidae (papillons de nuit ; 0,9%) et les Vespidae (guêpes ; 0,9%).
Les bactéries identifiées par l’approche basée sur la culture microbienne et le métabarcodage ont été comparées à la liste des agents biologiques du Health and Safety Executive (HSE, l’autorité compétente en matière d’Inspection du travail dans les domaines de la santé et sécurité au travail au Royaume-Uni). Et ce pour détecter la présence de bactéries pathogènes associées aux arthropodes domestiques. Le métabarcoding et l’approche basée sur la culture microbienne partageaient 10 familles de bactéries, toutes répertoriées dans la base de données du HSE comme potentiellement pathogènes. Une seule famille bactérienne de la base de données HSE a été identifiée uniquement par l’approche basée sur la culture microbienne. En revanche, 18 familles bactériennes ont été identifiées de manière unique par l’approche du métabarcoding (une approche sensible et informative !). Une corrélation positive significative a été trouvée entre les pathogènes humains isolés et les arthropodes d’intérieur, ainsi qu’entre les bactéries environnementales et les arthropodes d’extérieur. Cette corrélation est évidemment logique compte tenu de la biologie, de la localisation, des habitudes et du comportement des insectes et autres arthropodes.
L’approche du métabarcodage a permis d’identifier un plus grand nombre de bactéries pathogènes potentiellement opportunistes associées aux arthropodes domestiques. Cela permet de mieux comprendre le rôle des arthropodes non nuisibles en tant que porteurs d’agents pathogènes pour l’homme. L’étude fournit des informations importantes sur le rôle que les arthropodes non nuisibles peuvent jouer en tant que porteurs d’agents pathogènes opportunistes dans les ménages.
Quelles sont les autres recherches menées par l’université Aston sur les organismes nuisibles ?
– Une étude de l’université Aston a révélé que neuf insectes sur dix analysés dans des hôpitaux anglais étaient porteurs de bactéries potentiellement dangereuses, dont plus de la moitié étaient résistantes aux antibiotiques.
– Des « insectes avec des insectes » ont été collectés dans les zones de préparation des aliments et dans des services hospitaliers, y compris les unités de soins néonatals et de maternité.
– Les résultats soulignent l’importance des mesures de lutte contre les nuisibles dans les environnements de soins afin de prévenir les risques pour la santé publique.
Plus de 50 % des bactéries récupérées sur des insectes volants dans un groupe d’hôpitaux anglais étaient résistantes à un ou plusieurs antibiotiques, ce qui représente un risque potentiel d’infection pour les patients.
L’étude de l’université Aston a recueilli près de 20 000 échantillons d’insectes – y compris des mouches domestiques, des « mouches à détritus » bleues et vertes, et une variété de « moucherons des canalisations » – dans sept sites hospitaliers du NHS (le système de la santé publique du Royaume-Uni) en Angleterre. L’analyse microbiologique a révélé que près de neuf insectes sur dix étaient porteurs de bactéries potentiellement dangereuses telles que E. coli et Staphylococcus aureus, que ce soit à l’intérieur ou à l’extérieur de leur corps.
Des insectes volants porteurs de bactéries ont été collectés à plusieurs endroits dans les hôpitaux à l’aide de pièges à mouches à lumière ultraviolette (UV) et de tue-mouches électroniques. Il s’agissait notamment de zones où les aliments destinés aux patients, aux visiteurs et au personnel étaient préparés ou stockés, ainsi que de services, d’unités néonatales et de maternités. Dans certains cas, la quantité de bactéries transportées par les insectes volants était suffisante pour provoquer une infection.
Plus de 80 souches bactériennes ont été isolées à partir des échantillons d’insectes. Les entérobactéries – une famille qui comprend E. coli et diverses autres bactéries fécales ou intestinales – ont été les plus fréquemment isolées, représentant 41 % des isolations des insectes volants, suivies par les Bacillus (qui comprennent le « microbe de l’intoxication alimentaire », B. cereus) à 24 % et les staphylocoques (qui comprennent S. aureus, une cause d’infections cutanées, d’abcès et d’infections respiratoires) à 19 %.
L’analyse a montré que 53 % des souches étaient résistantes à une ou plusieurs classes d’antibiotiques. Sur ce chiffre, 19 % étaient résistantes à plusieurs antibiotiques, une caractéristique connue sous le nom de « multirésistance ». La pénicilline s’est révélée être l’antibiotique le moins efficace, de nombreuses bactéries y étant résistantes. Une résistance à d’autres antibiotiques couramment administrés, notamment la vancomycine et la lévofloxacine, a également été observée.
L’étude, publiée dans le très respecté Journal of Medical Entomology, a été réalisée en collaboration avec la Dr Federica Boiocchi, étudiante en doctorat, et le professeur Anthony Hilton, tous deux de l’école des sciences de la vie et de la santé de l’université Aston, ainsi qu’avec le Dr Matthew Davies, de la société Killgerm Chemicals Ltd.
Où trouver ces articles dans leur intégralité ?
L’étude la plus récente, décrite dans cet article, est disponible (en anglais) à l’adresse suivante : Boiocchi, F., Derelle, R., Davies, M., Orsini, L., & Hilton, A. (2021). Non-pest household arthropods as a reservoir of human opportunistic pathogens. Authorea (Authorea). https://doi.org/10.22541/au.163874802.28581869/v1
« An Examination of Flying Insects in Seven Hospitals in the United Kingdom and Carriage of Bacteria by True Flies », a été publiée dans le Journal of Medical Entomology en 2019. https://doi.org/10.1093/jme/tjz086
Les articles précédents du groupe de recherche, « The housefly Musca domestica as a mechanical vector of Clostridium difficile » et « Acquisition and retention of Clostridium difficile by Musca domestica larvae and pupae during metamorphosis » ont tous deux été publiés dans le Journal of Hospital Infection en 2016 et 2017 respectivement.
Les études précédentes ont décrit le potentiel de M. domestica adulte à contribuer à la persistance environnementale et à la propagation de la « superbactérie hospitalière » C. difficile dans les hôpitaux, soulignant que les mouches adultes sont des vecteurs potentiels réalistes de ce micro-organisme dans les zones cliniques. En outre, l’action antimicrobienne potentielle des larves de M. domestica et de leurs extraits contre les spores de C. difficile a été soulignée comme justifiant une étude plus approfondie. Davies, M., Anderson, M., & Hilton, A. (2016). The housefly Musca domestica as a mechanical vector of Clostridium difficile. The Journal Of Hospital Infection/Journal Of Hospital Infection, 94(3), 263‑267. https://doi.org/10.1016/j.jhin.2016.08.023